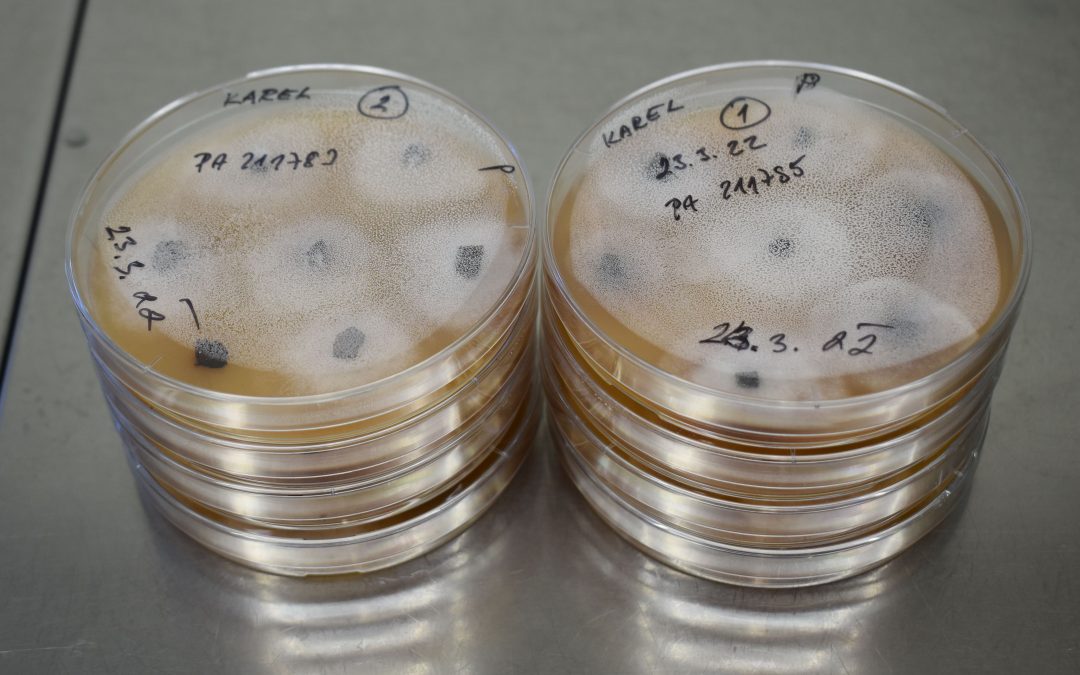
Českem se šíří plíseň olšová. Invazní patogen ohrožuje lužní a mokřadní olšiny

autor: Admin Vukoz | Bře 28, 2025 | Aktuality
Workshop Využití vrb pro haťování bystřin Dne 25. 3. 2025 proběhl ve Výzkumném ústavu pro krajinu (VÚK) workshop projektu NAKI „Autonomní systémy pokročilých a přírodě blízkých opatření pro režim péče a zlepšení kvality vody v památkách zahradního umění“ Botanického...

autor: Admin Vukoz | Bře 17, 2025 | Aktuality, Aktuality kulturní krajina
Britští botanici navštívili Průhonice za účelem mezinárodní spolupráce na ochraně jeřábů Ve dnech 5. až 6. března 2025 zavítali do Výzkumného ústavu pro krajinu v Průhonicích dvě přední britské osobnosti v oblasti ochrany jeřábů (rod Sorbus), Dan Crowley a Rosalyn...

autor: Admin Vukoz | Bře 12, 2025 | Aktuality, Tiskové zprávy
Českem se šíří plíseň olšová. Invazní patogen ohrožuje lužní a mokřadní olšiny V důsledku globalizace obchodu s rostlinným materiálem a zavlékání nepůvodních druhů rostlin dochází v posledních letech k exponenciálnímu nárůstu invazních patogenů v naší přírodě. Některé...

autor: Admin Vukoz | Bře 5, 2025 | Aktuality
Metodika oceňování okrasných rostlin na trvalém stanovišti k dostání zdarma Vychází aktualizovaná Metodika oceňování okrasných rostlin na trvalém stanovišti. Je určena k zjišťování ceny stromů, keřů, pnoucích dřevin, růží, trvalek, neprodukčních (okrasných) trávníků,...